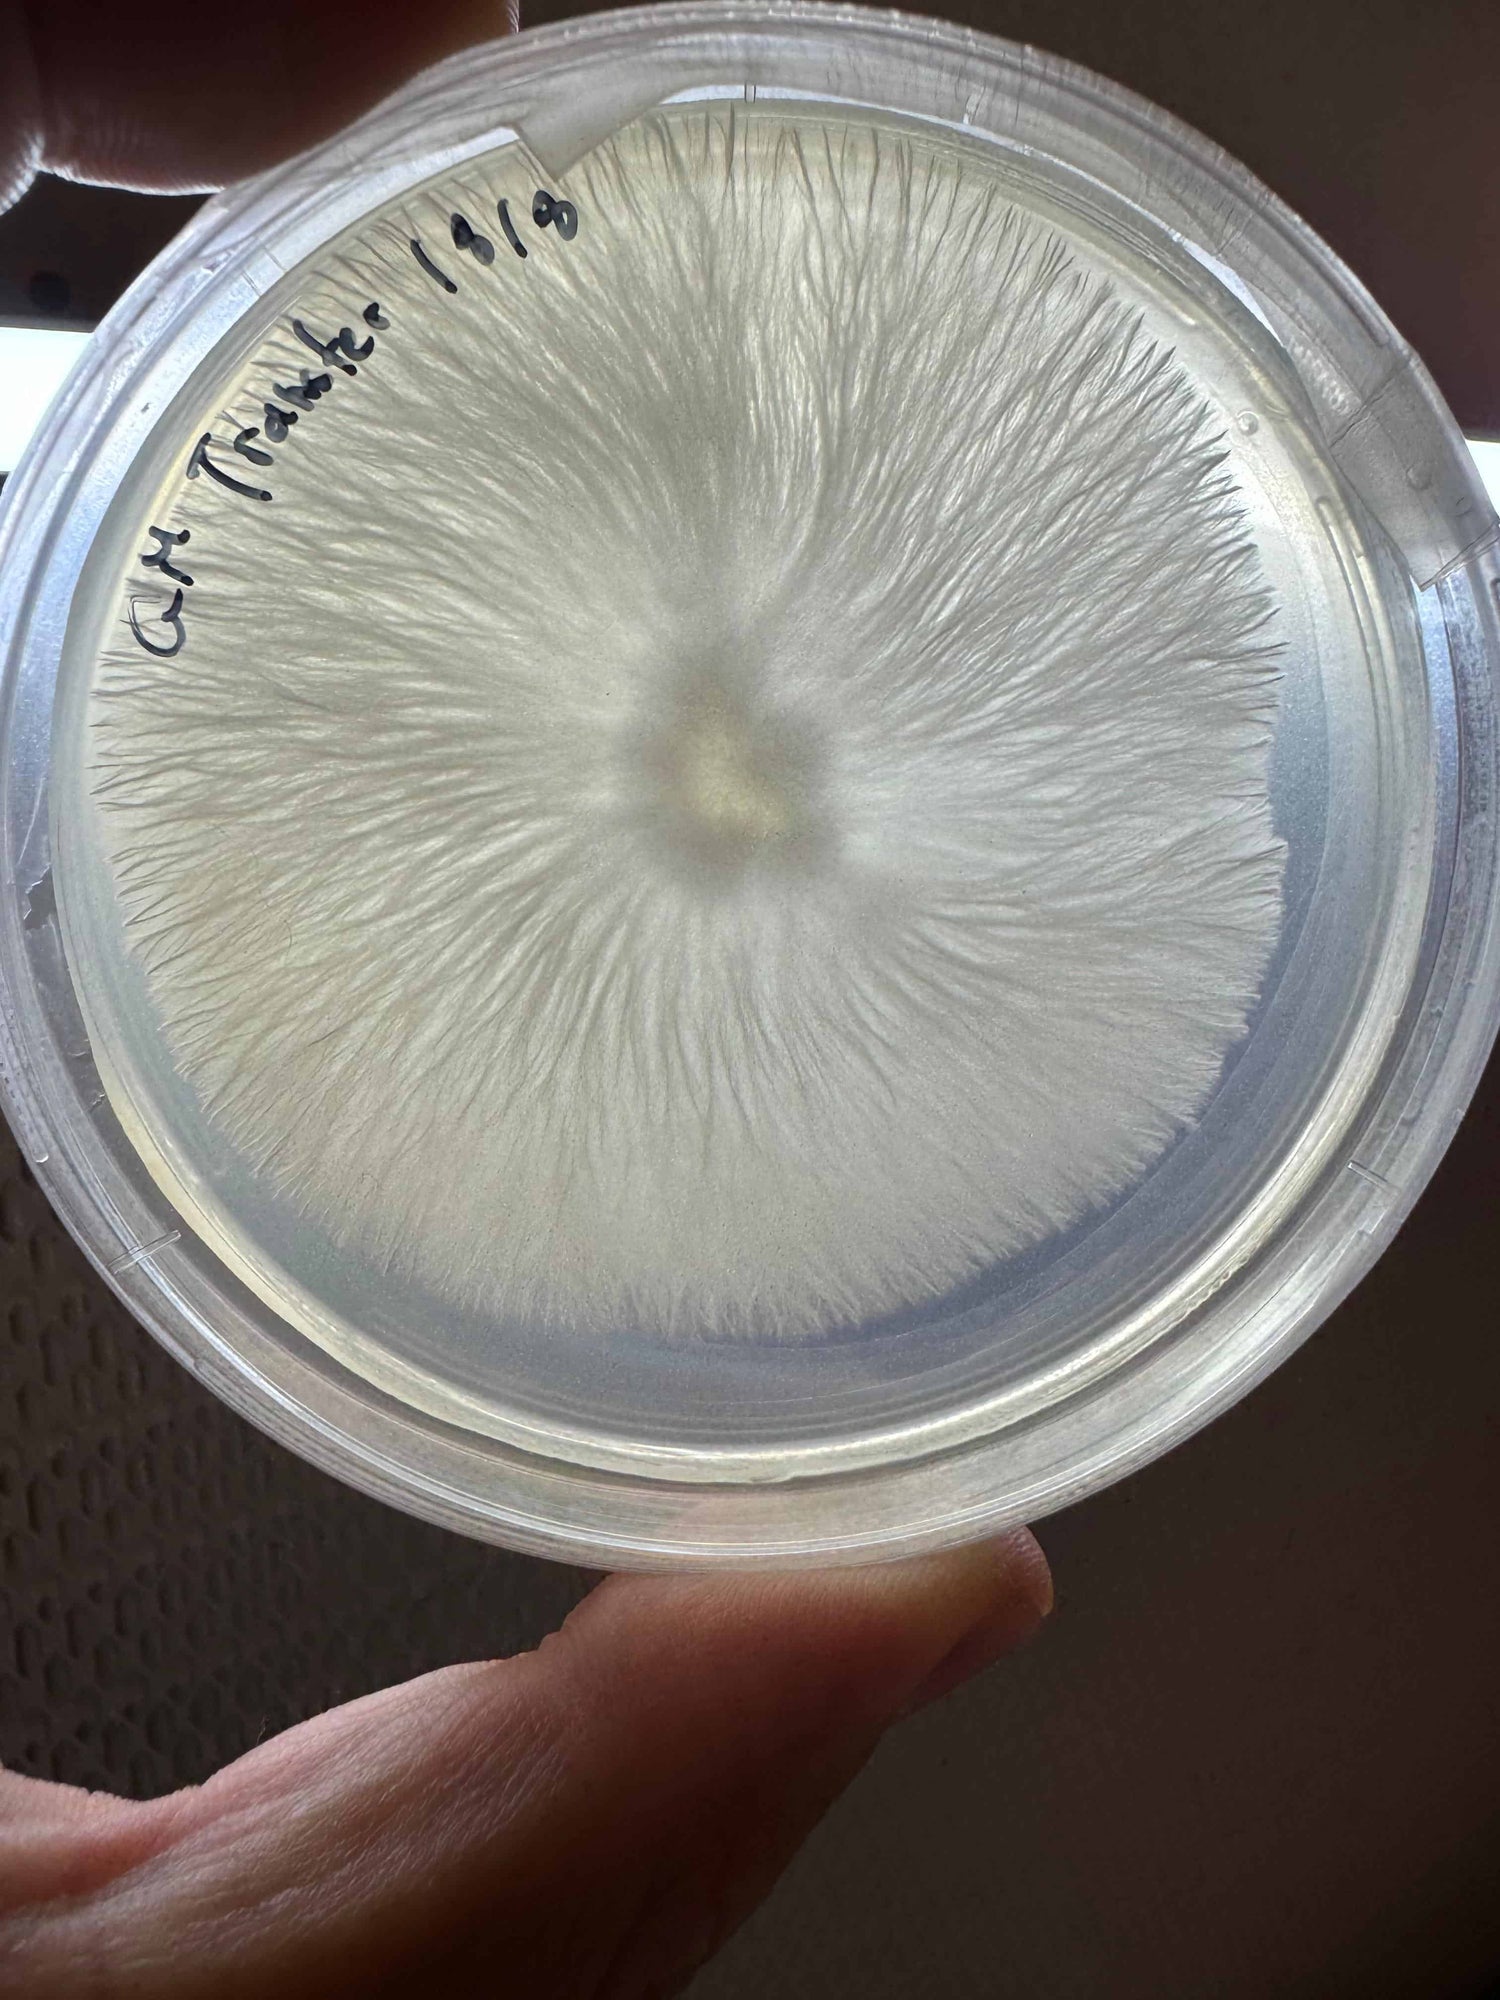

Ramadan special Bundle
Energy, Calm & Immunity
⭐⭐⭐⭐⭐ 4.9/5 Reviews
Ancient Mushrooms. Limitless Potential.
Just Landed!
Mushies New Collection with 30% more potency
-
Full Spectrum 7Full Spectrum 7
- Regular price
-
From
$24.99 - Regular price
-
$30.00 - Sale price
-
From
$24.99
Choose options –17%Quick view
-
Focus & MemoryFocus & Memory
- Regular price
-
From
$19.99 - Regular price
-
$25.00 - Sale price
-
From
$19.99
Choose options –21%Quick view
-
Energy & FocusEnergy & Focus
- Regular price
-
From
$21.99 - Regular price
-
$27.00 - Sale price
-
From
$21.99
Choose options –19%Quick view
-
Immunity & GutImmunity & Gut
- Regular price
-
From
$19.99 - Regular price
-
$25.00 - Sale price
-
From
$19.99
Choose options –21%Quick view
-
Energize +Energize +
- Regular price
-
From
$19.99 - Regular price
-
$25.00 - Sale price
-
From
$19.99
Choose options –21%Quick view
Where to find Mushies

Organic & Lab-Tested for Maximum Benefits
We combine time-tested mushroom benefits with cutting-edge natural extraction methods to bring you the cleanest, most effective functional mushroom powders.
The Ultimate Mushroom Blend
7 Powerful Mushrooms, 1 Game-Changing Formula




⭐️⭐️⭐️⭐️⭐️ 30,000+ Reviews
Full Spectrum 7
🌈 Total-body support: energy, focus, calm, immunity
🥄 Simplifies routines – one scoop covers all bases
🎯 For holistic newbies or lazy wellness pros
- Regular price
-
$24.99 - Regular price
-
$30.00 - Sale price
-
$24.99





Meet the 7 Superheroes
-
Lion's Mane
"The Brain Mushroom"
Improves Cognition, Memory, Creativity and Focus | Protects brain cells from diseases
-
Cordyceps
"The Energy Mushroom"
Improves athletic performance and Endurance | Increases Libido
-
Reishi
"The Zen Mushroom"
Mood Enhancer and Stabilizer | Anti-Anxiety | Anti-Stress | Sleep quality enhancer
-
Turkey Tail
"The Immunity Mushroom"
Strengthens and Regulates Immunity | Balances gut bacteria | Fights cancer cells
-
Chaga
"The Detox Mushroom"
Highest anti-oxidant ingredient in the world - Full Detox
-
Tremella
"The Beauty Mushroom"
Boosts hydration and collagen production | Promotes youthful skin
-
Shiitake
"The Heart Mushroom"
Supports cardiovascular health | helps controlling cholesterol levels
Mushies Bundles
-
Ramadan Special BundleRamadan Special Bundle
- Regular price
-
$54.99 - Regular price
-
$75.00 - Sale price
-
$54.99
Add to cart –27%Quick view
-
Glow & Renew BundleGlow & Renew Bundle
- Regular price
-
$56.99 - Regular price
-
$77.00 - Sale price
-
$56.99
Add to cart –26%Quick view
-
Immune Shield BundleImmune Shield Bundle
- Regular price
-
$59.99 - Regular price
-
$80.00 - Sale price
-
$59.99
Add to cart –26%Quick view
-
Peak Productivity BundlePeak Productivity Bundle
- Regular price
-
$56.99 - Regular price
-
$77.00 - Sale price
-
$56.99
Add to cart –26%Quick view
-
Performance Boost BundlePerformance Boost Bundle
- Regular price
-
$59.99 - Regular price
-
$77.00 - Sale price
-
$59.99
Add to cart –23%Quick view
-
Starter KitStarter Kit
- Regular price
-
$39.99 - Regular price
-
$52.00 - Sale price
-
$39.99
Add to cart –24%Quick view
-
Ultimate KitUltimate Kit
- Regular price
-
$99.99 - Regular price
-
$152.00 - Sale price
-
$99.99
Add to cart –35%Quick view
A Journey Through Nature & Science
The Mushies Origin Story
It all started with a simple question: What if the key to better health was growing right beneath our feet?
At Mushies, we’ve always believed in the profound power of nature. But finding pure, potent, and effective mushroom supplements? That was a different story.






The Ritual
How to Upgrade Your Daily Routine
Transform your morning, workout, or wind-down with a simple, game-changing addition: MUSHIES.


The Mushies Challenge
Feel the Difference in 30 Days
Ready to unlock better energy, focus, and well-being? Take the Mushies 30-Day Challenge and experience the transformation for yourself.
Join 30,000+ Mushies Drinkers
See What Mushies Fans Are Saying
The Mushies Promise
-
Lab-Tested for Purity
-
Trusted by 30,000+ Drinkers
-
Fast & Reliable Delivery
-
24/7 Customer Support